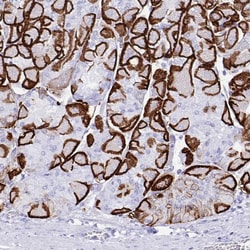
Invitrogen Aquaporin 4 Polyclonal Antibody 100 &mu;L; Unconjugated:Antibodies

missing translation for 'onlineSavingsMsg'
Learn More
Learn More
Invitrogen™ Aquaporin 4 Polyclonal Antibody


Rabbit Polyclonal Antibody
Marca: Invitrogen™ PA553234
Questo articolo non è restituibile.
Consulta la politica di reso
Descrizione
Immunogen sequence: CPDVEFKRRF KEAFSKAAQQ TKGSYMEVED NRSQVETDDL ILKPGVVHVI DVDRGEEKKG KDQSGEVLSS V Highest antigen sequence identity to the following orthologs: Mouse - 93%, Rat - 92%.
In skeletal muscle, AQP4 (aquaporin 4 also known as mercurial insensitive water channel), localizes to the sarcolemma of fast-twitch muscle fibers. Aquaporins (AQPs) are a large family of integral membrane water transport channel proteins that facilitate the transport of water through the cell membrane. This function is conserved in animals, plants and bacteria. Many isoforms of aquaporin have been identified in mammals, designated AQP0 through AQP10. Aquaporins are widely distributed and it is not uncommon for more than one type of AQP to be present in the same cell. Although most aquaporins are only permeable to water, AQP3, AQP7, AQP9 and one of the two AQP10 transcripts are also permeable to urea and glycerol.
Specifica
| Aquaporin 4 | |
| Polyclonal | |
| Unconjugated | |
| AQP4 | |
| Aqp4; AQP-4; aquaporin 4; aquaporin type4; Aquaporin4; aquaporin-4; HMIWC2; Mercurial-insensitive water channel; MGC22454; MIWC; MIWC2; WCH4 | |
| Rabbit | |
| Antigen affinity chromatography | |
| RUO | |
| 11829, 361 | |
| Store at 4°C short term. For long term storage, store at -20°C, avoiding freeze/thaw cycles. | |
| Liquid |
| Immunohistochemistry (Paraffin), Western Blot, Western Blot | |
| 0.30 mg/mL | |
| PBS with 40% glycerol and 0.02% sodium azide; pH 7.2 | |
| P55087, P55088 | |
| AQP4 | |
| Recombinant protein corresponding to Human Aquaporin 4. Recombinant protein control fragment (Product #RP-91109). | |
| 100 μL | |
| Primary | |
| Human, Mouse | |
| Antibody | |
| IgG |
Correzione del contenuto del prodotto
Fornite il vostro feedback sul contenuto del prodotto compilando il modulo sottostante.
Titolo del prodotto
Individuate un'opportunità di miglioramento?Condividi una correzione di contenuto